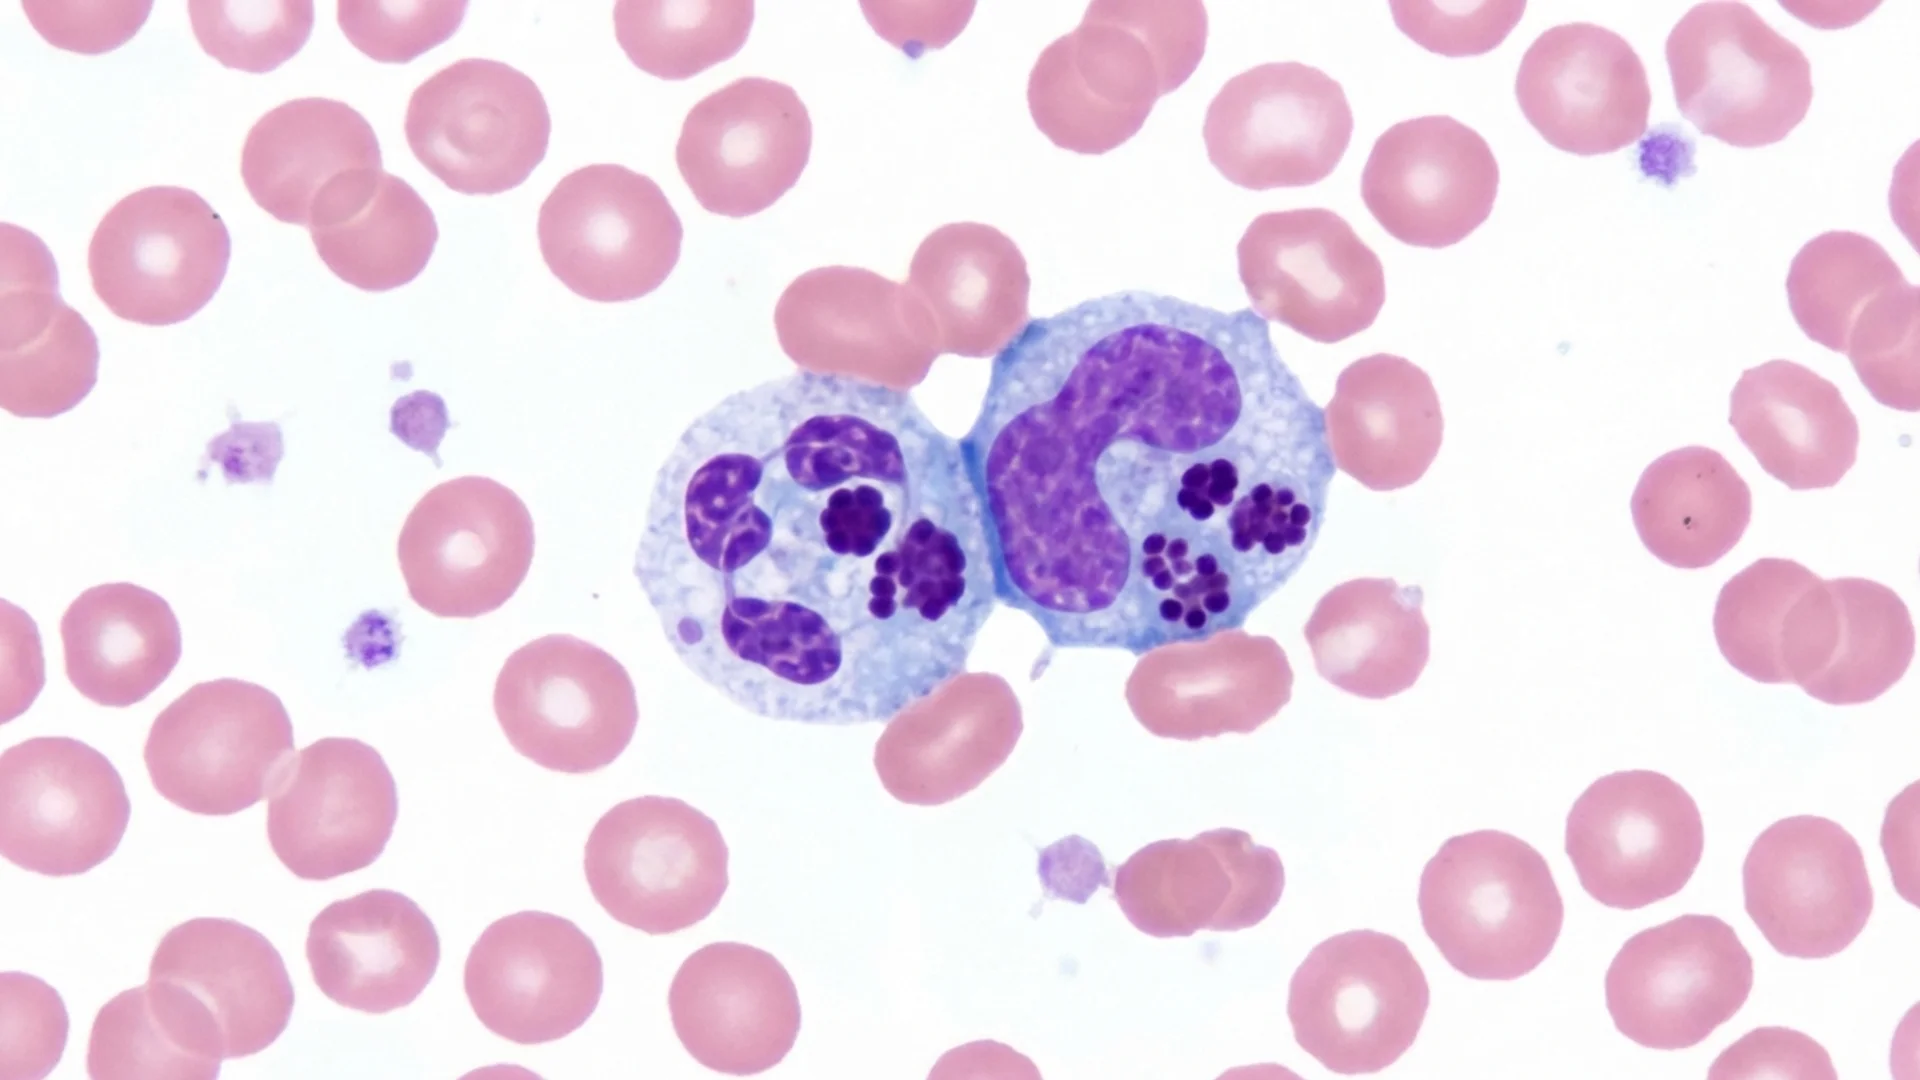
Ehrlichia and Anaplasma
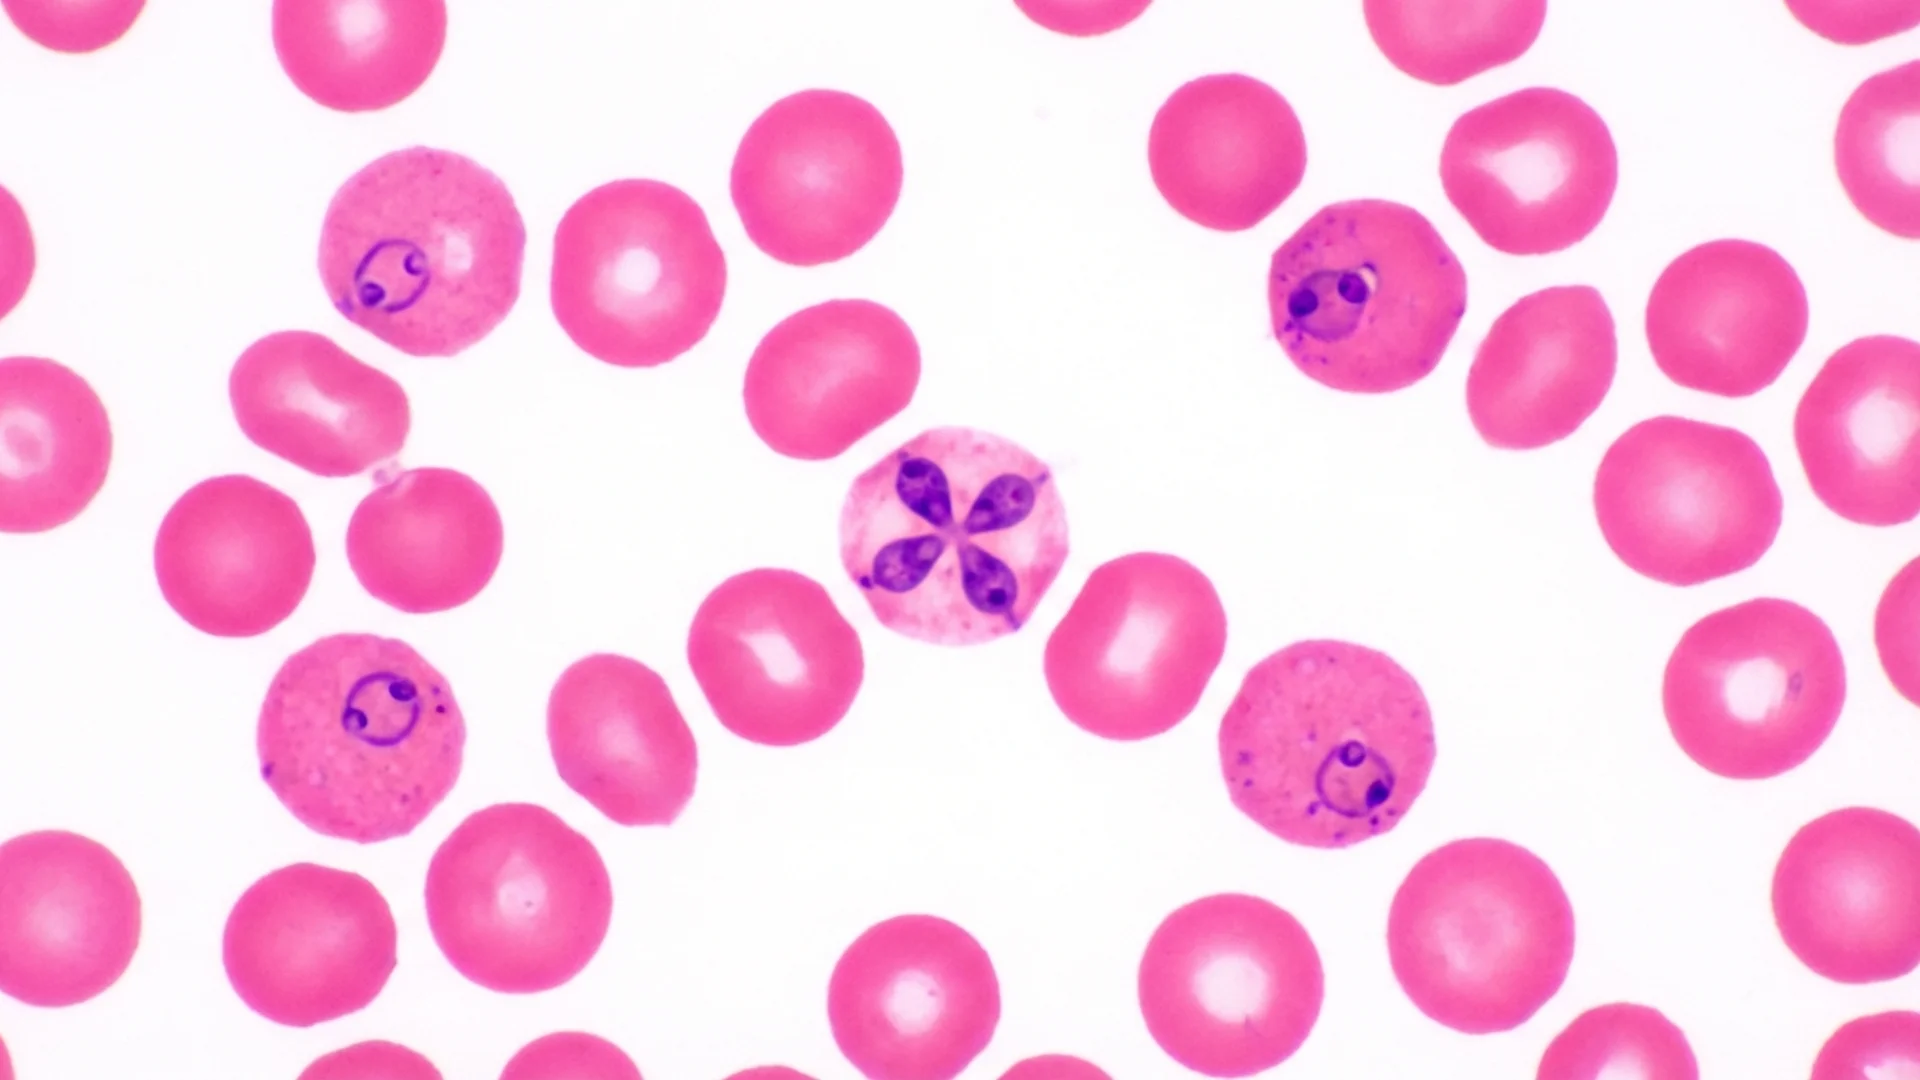
Babesia: The Parasitic Co-Infection

Showing 293 articles

Semax: The Nootropic Peptide That Amplifies BDNF and Protects the Brain
Semax is a synthetic ACTH-derived peptide that upregulates BDNF, enhances focus and memory, and offers neuroprotection — used clinically in Russia for decades.

Alpha-Ketoglutarate (AKG): A Physician's Guide to the Longevity Molecule
Dr. Julian Douwes reviews the evidence on alpha-ketoglutarate (AKG) supplementation — from TCA cycle biochemistry to epigenetic aging and clinical dosing.

IV Glutathione Therapy: Clinical Uses, Dosing Protocols, and What to Expect
A physician's guide to IV glutathione therapy — indications, dosing protocols, clinical evidence, and how it compares to oral and liposomal forms.

Exosome Therapy for Regeneration and Longevity: A Physician's Evidence Review
Dr. Douwes reviews exosome therapy—what exosomes are, the clinical evidence for regeneration and anti-aging, dosing protocols, and how to evaluate providers safely.

Taurine and Longevity: A Physician's Evidence Review
Dr. Julian Douwes examines taurine's role in aging, the landmark 2023 Science study, clinical dosing protocols, and who stands to benefit most.

PEMF Frequency Guide: Which Hz Settings Treat Which Conditions
Physician's guide to PEMF frequency selection—from 1 Hz sleep protocols to 100 Hz inflammation reduction. Know which settings match your condition.

Peptide Therapy Benefits: A Physician's Evidence-Based Overview
Dr. Douwes reviews the clinically relevant benefits of peptide therapy — from tissue repair and immune modulation to longevity and brain health. What evidence supports each claim.

Resveratrol and Longevity: What the Clinical Evidence Actually Shows
A physician's review of resveratrol's SIRT1 activation, cardiovascular and neuroprotective data, bioavailability limits, and practical dosing for longevity.

Best Peptides for Healing: A Physician's Ranked Guide to Tissue Repair
Dr. Julian Douwes ranks the most effective peptides for tissue repair, wound healing, and recovery — with dosing context and evidence grades for each.

Hyperbaric Oxygen Therapy for Longevity and Recovery: A Physician's Review
Dr. Douwes reviews hyperbaric oxygen therapy (HBOT): how it works, what the clinical evidence says for longevity, post-COVID, Lyme, and neurological recovery.

Alpha-Lipoic Acid: Neuropathy, Heavy Metal Detox, and Mitochondrial Repair
Dr. Douwes reviews alpha-lipoic acid dosing, R-ALA vs racemic forms, clinical uses for neuropathy, heavy metal chelation support, and mitochondrial longevity.

NAD Supplement Guide: NMN, NR, NADH and Oral NAD+ Precursors Compared
A physician's comparison of every oral NAD+ precursor — NMN, NR, NADH, and NAD3 — covering mechanisms, dosing, cofactors, and when to upgrade to IV therapy.

Low-Dose Naltrexone (LDN): Clinical Evidence for Chronic Illness and Autoimmunity
Low-dose naltrexone modulates immune function and reduces neuroinflammation. Evidence-based overview of LDN dosing, mechanisms, and clinical applications.

Heavy Metal Chelation Therapy: A Physician's Clinical Protocol
Dr. Julian Douwes explains heavy metal chelation therapy — which agents to use, when to use them, how to prepare, and how to monitor safely in clinical practice.

IV Laser Therapy: A Physician's Complete Guide to Intravenous Photobiomodulation
A physician's guide to intravenous laser blood irradiation: mechanisms, clinical evidence, treatment protocols, and who benefits most from ILBI therapy.

Ashwagandha and Cortisol: What the Clinical Evidence Actually Shows
How ashwagandha (KSM-66, Sensoril) lowers cortisol, calms the HPA axis, and reduces chronic stress — with dosing, timing, and safety from a physician's perspective.

Berberine and Blood Sugar: Mechanisms, Evidence, and Clinical Protocols
Dr. Douwes breaks down how berberine lowers blood sugar, what the clinical trials actually show, and the dosing protocol he uses in practice.

Cold Plunge Science: What Cold Water Immersion Does to Your Body
A physician's evidence-based breakdown of cold plunge physiology — from norepinephrine spikes to metabolic shifts, and how to dose cold water immersion safely.

Urolithin A: Activating Mitophagy for Muscle Health and Longevity
Dr. Douwes reviews urolithin A — the gut-derived metabolite that activates mitophagy, preserves muscle function, and extends healthspan in clinical trials.

Apheresis for Autoimmune Disease: A Physician's Clinical Guide to Blood Purification Therapy
How extracorporeal apheresis reduces autoantibody burden, inflammatory cytokines, and immune complex load in treatment-resistant autoimmune conditions.

Spermidine and Longevity: The Autophagy Activator Your Cells Are Waiting For
Spermidine triggers cellular autophagy, protects cardiovascular and cognitive health, and extends lifespan in animal models. What the human evidence actually shows.

CoQ10 for Heart Health: What the Clinical Evidence Actually Shows
Cardiologist-reviewed guide to CoQ10 for heart failure, hypertension, and statin-related symptoms. Dosing, forms, and who benefits most.

Ozone Therapy Risks: A Physician's Honest Assessment
A clinical breakdown of ozone therapy risks by administration route, contraindications, and how to evaluate whether ozone treatment is appropriate for you.

Magnesium for Sleep: Which Form Works Best and Why
Dr. Julian Douwes reviews the clinical evidence on magnesium for sleep — comparing glycinate, threonate, and oxide, with dosing protocols used in integrative practice.

Photobiomodulation for Depression: What the Clinical Evidence Actually Shows
Dr. Douwes reviews transcranial photobiomodulation for depression — mechanisms, clinical trial data, dosing protocols, and how it fits an integrative mental health strategy.

Ozone Therapy vs. IV Laser Therapy: A Physician's Clinical Comparison
Dr. Douwes compares ozone therapy and IV laser therapy—mechanisms, clinical indications, safety profiles, and when to combine both in integrative practice.

BPC-157 Oral vs Injection: Which Route Delivers Better Results?
Physician comparison of BPC-157 oral capsules versus subcutaneous injection — covering bioavailability, onset, dosing, and clinical use cases for each route.

Ubiquinol vs Ubiquinone: Which Form of CoQ10 Actually Works Better?
Ubiquinol vs ubiquinone: understand the biochemical difference, absorption data, and when each form is clinically appropriate for your patients.

NAD+ IV Side Effects: What to Expect and How to Manage Them
A physician's guide to NAD+ IV therapy side effects: what causes them, which are common vs serious, how to minimize discomfort, and who should avoid treatment.

Ozone Therapy Evidence: What the Clinical Research Actually Shows
A physician's analysis of ozone therapy evidence across chronic infections, post-COVID, wound healing, and autoimmunity — mechanisms, delivery methods, and realistic expectations.

Peptide Therapy for Women: What the Clinical Evidence Actually Shows
A physician's evidence-based guide to peptide therapy for women — covering hormonal interactions, key peptides, dosing considerations, and who is a suitable candidate.

Anti-Aging Supplements: A Physician's Actual Stack for Longevity
A practicing physician's evidence-based anti-aging supplement stack. NAD+, resveratrol, CoQ10, omega-3, vitamin D — what works, what's overhyped, and what I actually take.

H.E.L.P. Apheresis vs INUSpheresis: What the Evidence Shows
Clinical comparison of H.E.L.P. Apheresis and INUSpheresis. Mechanisms, evidence quality, patient selection, and what I observe in practice at Klinik St. Georg.

Hyperthermia Treatment for Cancer: What the Evidence Shows
How hyperthermia cancer treatment works, evidence levels, clinical experience at Klinik St. Georg, types, and what patients should expect. Written by a physician.

Whole-Body Hyperthermia for Lyme Disease: Evidence, Mechanism, and Clinical Protocols
Comprehensive guide to whole-body hyperthermia for chronic Lyme disease. Mechanism of action, evidence base, clinical protocols, and patient outcomes from a physician who performs it.

Lyme Disease Treatment in Germany: Why Patients Travel for Care
Why patients travel to Germany for Lyme disease treatment. German clinic advantages, treatment approaches, costs, logistics, and what to expect at Klinik St. Georg.

NAD+ Injections vs Oral Supplements: Which Delivery Method Works?
NAD+ IV injections vs oral NMN vs sublingual NAD+ compared. Bioavailability data, clinical outcomes, cost analysis, and what I recommend in practice.

How Much Does Peptide Therapy Cost? A Transparent Breakdown
Transparent peptide therapy cost breakdown from a physician. Consultation, peptides, monitoring labs, German vs US pricing, and insurance considerations explained.

Is Peptide Therapy FDA Approved? The Honest Regulatory Picture
Honest physician's answer about FDA approval for peptide therapy. Which peptides are approved, which are investigational, off-label use, and the European regulatory landscape.

Does Insurance Cover Peptide Therapy? A Realistic Guide
Honest guide to insurance coverage for peptide therapy. What is covered, what is not, German vs US insurance landscape, HSA/FSA options, and strategies to reduce out-of-pocket costs.

Peptides for Muscle Growth: What the Evidence Actually Supports
Evidence-based review of peptides for muscle growth. GH secretagogues, BPC-157 for recovery, safety risks, and what works based on clinical experience.

BPC-157 Side Effects: What Patients Actually Report
Honest physician assessment of BPC-157 side effects, contraindications, FDA status, and what patients report. Evidence levels clearly distinguished.

TB-500 (Thymosin Beta-4): A Physician's Complete Guide
TB-500 overview from a practicing physician. Mechanism, evidence for tissue repair, dosing protocols, side effects, and clinical applications of Thymosin Beta-4.

Stem Cell Therapy for Lyme Disease: An Honest Evidence Review
Honest physician's assessment of stem cell therapy for Lyme disease. Current evidence level, what patients should know, legitimate applications vs red flags in stem cell tourism.

What Is Peptide Therapy? A Physician's Complete Guide
What peptide therapy is, how it works, FDA status, costs, and what to expect. Written by a physician who prescribes peptides daily in clinical practice.

What to Expect at Your First Apheresis Session: A Patient's Guide
Step-by-step guide to your first apheresis session. Preparation, procedure, duration, aftercare, and what patients commonly feel — from a physician who performs apheresis daily.

What to Expect: H.E.L.P. Apheresis Treatment
Your complete guide to the H.E.L.P. apheresis experience at Klinik St. Georg. From blood draw to filtration to recovery — what each session actually feels like.

What I Changed My Mind About: Long-Term Antibiotics for Chronic Lyme
A physician's honest account of evolving clinical perspective on long-term antibiotic therapy for chronic Lyme disease, and what changed.

What to Expect: Whole-Body Hyperthermia Treatment Day by Day
A day-by-day walkthrough of whole-body hyperthermia at Klinik St. Georg. From consultation to recovery, what happens at every stage of your treatment journey.

H.E.L.P. Apheresis vs INUSpheresis: Which Blood Filtration Therapy?
A physician's comparison of H.E.L.P. Apheresis and INUSpheresis — filtering mechanisms, indications, evidence, cost, and which patients benefit from each approach.

Whole-Body Hyperthermia vs IV Antibiotics for Lyme Disease
A physician's comparison of whole-body hyperthermia and IV antibiotics for Lyme disease — mechanisms, evidence, recurrence rates, and when each approach is appropriate.

Fisetin vs Quercetin: Which Senolytic Flavonoid Is Better?
A physician's comparison of fisetin and quercetin as senolytic agents — mechanisms, evidence, dosing protocols, and which patients benefit from each flavonoid.

Treatment Costs: What to Expect
Transparent guide to treatment costs at Klinik St. Georg. Cost ranges, what is included, insurance coverage, payment options, and comparison to US treatment costs.

International Patients: Your Complete Guide to Treatment in Germany
Visa requirements, travel insurance, language support, airport transfers, and accommodation for international patients traveling to Klinik St. Georg in Germany.

Why Germany for Integrative Medicine?
Why patients travel to Germany for integrative medicine. The German medical system, regulatory framework, insurance landscape, and tradition of combining conventional and complementary medicine.

After Treatment: Recovery and Follow-Up Protocols
What to expect after treatment at Klinik St. Georg. First 48 hours, two-week recovery, ongoing protocols, lab monitoring, and when to contact the clinic.

Your First Consultation: What We Assess and Why
What happens during your first consultation at Klinik St. Georg. The labs we order, the intake process, how we build your treatment plan, and realistic timelines.

Preparing for Your Visit to Klinik St. Georg
Everything you need to prepare before traveling to Klinik St. Georg in Germany. Medical records, travel logistics, packing list, and what happens on day one.

CJC-1295/Ipamorelin vs Tesamorelin: Growth Hormone Secretagogues Compared
A physician's comparison of CJC-1295/Ipamorelin and tesamorelin — mechanisms, evidence, body composition effects, and which GH secretagogue suits which patient.

Semaglutide vs Tirzepatide: GLP-1 Therapies Compared
A physician's comparison of semaglutide and tirzepatide — mechanisms, weight loss data, metabolic benefits, side effects, and which patients benefit from each.

Western Blot vs ELISA: Lyme Testing Accuracy Compared
Head-to-head comparison of Western Blot and ELISA for Lyme disease. Sensitivity at each stage, what the bands mean, the two-tier protocol, and why the system misses patients.

Labs Your Doctor Won't Order (But Should)
Essential functional medicine labs most doctors skip. hs-CRP, fasting insulin, homocysteine, full thyroid, ApoB, and more — what to request and why it matters.

Neurofeedback for Lyme Brain Fog
How neurofeedback retrains dysregulated brainwave patterns in Lyme disease patients. qEEG findings, clinical evidence, and what to expect from treatment.

TB-500 Dosage: Loading, Maintenance, and Cycling
Evidence-based TB-500 dosing protocols. Loading and maintenance phases, injection frequency, cycling schedules, and clinical dosing rationale.

Best Probiotic Strains by Condition: IBS, Bloating, Immunity, and Mood
Physician guide to evidence-based probiotic strain selection. Which specific strains work for IBS, bloating, immunity, mood, and vaginal health, with dosing and evidence grades.

Babesia and Air Hunger: Why You Can't Catch Your Breath
Why Babesia causes air hunger — the autonomic and hemolytic mechanisms behind this hallmark symptom, and what it means for diagnosis and treatment.

Babesia Treatment Failure: What to Do When Standard Therapy Doesn't Work
Options beyond atovaquone-azithromycin for relapsing babesiosis. Combination protocols, herbal adjuncts, and when exchange transfusion is considered.

DSIP Dosage and Protocol for Sleep
Evidence-based DSIP dosing guide for sleep. Subcutaneous protocols, timing, cycling, and realistic expectations from Dr. Julian Douwes.

NAC vs. Glutathione: Which Antioxidant Should You Take?
Physician comparison of NAC vs glutathione supplements. Oral bioavailability, mechanisms, when to use each, liposomal glutathione, and evidence-based recommendations.

Chelation Therapy Side Effects and Safety
Complete guide to chelation therapy side effects. Common reactions, serious risks, mineral depletion, monitoring requirements, and how to minimize adverse effects.

Neurofeedback vs Biofeedback: Which Do You Need?
Clear comparison of neurofeedback and biofeedback. What each measures, how they work, conditions they treat, and how to choose the right one for your situation.

Vitamin D: The Most Important Supplement Most People Get Wrong
Vitamin D benefits and dosing from a physician. Optimal levels, cofactors K2 and magnesium, immune modulation, LL-37 upregulation, and why most people are deficient.

PEMF for Lyme Disease and Chronic Pain
How pulsed electromagnetic field therapy supports pain relief and inflammation reduction in Lyme disease — mechanism, clinical evidence, and practical considerations.

At-Home Vagus Nerve Exercises: Evidence-Based Techniques
Evidence-based vagus nerve exercises you can do at home — diaphragmatic breathing, cold exposure, humming, and why starting slow matters for dysautonomia patients.

Berberine vs Metformin: AMPK Activation Compared
Head-to-head comparison of berberine and metformin for glucose control, lipids, and longevity. Both activate AMPK — but how do they really compare?

NAD+ IV vs NMN vs NR: Which NAD Precursor Is Best?
NAD+ IV, NMN, and NR compared by a physician. Bioavailability, evidence, cost, and who benefits from which approach based on clinical experience.

Pentosan Polysulfate for Knee Osteoarthritis
Pentosan polysulfate for knee OA by Dr. Julian Douwes. Disease-modifying potential, subcutaneous protocols, cartilage repair evidence, and comparison with hyaluronic acid.

Lyme Treatment: Germany vs the United States
A direct comparison of American IDSA Lyme guidelines and German integrative Lyme treatment. Why patients travel to Germany, what's different, and what the evidence supports.

Mold Testing: Urine Mycotoxins vs ERMI vs Air Testing
Comparing mold testing methods — urine mycotoxin testing for body burden, ERMI for environmental exposure, and air sampling limitations. Which test you actually need.

Vagus Nerve Stimulation for Chronic Fatigue and POTS
How vagus nerve stimulation restores autonomic balance in chronic fatigue and POTS — the cholinergic anti-inflammatory pathway, clinical evidence, and treatment options.

Epithalon vs NMN: Anti-Aging Mechanisms Compared
Epithalon vs NMN comparison by Dr. Julian Douwes. Telomere lengthening vs NAD+ replenishment — different aging hallmarks, different evidence, and when to use each.

CoQ10 for Statin Users: Why Your Cholesterol Medication Depletes CoQ10
Physician guide to CoQ10 depletion from statins. Why it happens, symptoms of statin-induced CoQ10 deficiency, optimal dosing with ubiquinol, and what the evidence shows.

How to Choose a Probiotic: CFU Count, Strains, and What Actually Matters
Physician guide to choosing a probiotic supplement. CFU count myths, strain identification, delivery mechanisms, third-party testing, and what the label should tell you.

LL-37 and Vitamin D: The Immune Connection
How vitamin D regulates LL-37 production and why this matters for immunity. The cathelicidin pathway, optimal levels, and clinical implications.

TB-500 for Tendon and Ligament Repair
How TB-500 supports tendon and ligament healing. Mechanisms, preclinical evidence, clinical observations, and practical protocols for connective tissue.

CoQ10 Dosage by Condition: Heart, Fertility, Migraines, and Energy
Physician guide to CoQ10 dosing by condition. Ubiquinol vs ubiquinone, heart health, male fertility, migraine prevention, energy, and statin users. Evidence-based protocols.

Managing Herxheimer Reactions at Home
Evidence-based strategies for managing Jarisch-Herxheimer reactions during Lyme treatment — hydration, detox support, dose pacing, and when to call your doctor.

CJC-1295/Ipamorelin Dosage: Growth Hormone Protocol
Evidence-based CJC-1295/Ipamorelin dosing guide by Dr. Julian Douwes. Nightly subcutaneous protocols, DAC vs no-DAC, cycling, and growth hormone optimization.

DSIP vs Melatonin: Which Sleep Peptide?
DSIP vs melatonin comparison by Dr. Julian Douwes. Sleep architecture modulation vs circadian timing — mechanisms, evidence levels, and when to use each.

Organic Acids Test (OAT): What It Reveals
Complete guide to the Organic Acids Test. What the 70+ markers mean, what OAT reveals about mitochondrial function, neurotransmitters, and gut health, and when to order it.

Is Herxing a Good Sign? What Die-Off Actually Means
Does a Herxheimer reaction mean treatment is working? The science behind die-off, why worse does not always mean better, and the goal of controlled pathogen clearance.

How Reactivated Viruses Suppress Your Immune System
The immune suppression cascade: how Lyme disease triggers EBV, HHV-6, and CMV reactivation, and how these viruses further suppress immunity in a vicious cycle.

CD57 Test in Lyme Disease: Useful or Unreliable?
The CD57 test in Lyme disease — what it measures, Dr. Stricker's original hypothesis, conflicting study results, and how clinicians actually use it in practice.

PEMF Therapy Side Effects: What to Expect
What to expect during and after PEMF therapy — common responses, contraindications, how to titrate sessions, and when temporary symptom increases are normal.

When to Take Supplements: The Complete Timing Guide
Evidence-based supplement timing guide. Fat-soluble vitamins with meals, magnesium at night, iron on an empty stomach, and how to build morning and evening stacks based on pharmacokinetics.

iSpot Lyme T-Cell Test: A Better Way to Detect Borrelia?
How the iSpot Lyme (ELISpot) T-cell test works, its advantages over antibody testing, 84% sensitivity data, limitations, and when it adds clinical value.

Bartonella Herbal Treatment Protocols
Evidence-based herbal protocols for Bartonella including Cryptolepis, Japanese Knotweed, and Cat's Claw — what the research shows and how clinicians use them.

Why Antibiotics Alone Fail Against Biofilms
How bacterial biofilms reduce antibiotic efficacy by 100-1,000x, why standard treatment courses miss persistent infections, and what integrative approaches add.

KPV for Gut Inflammation: IBD, Colitis, and Clinical Evidence
How the KPV tripeptide reduces gut inflammation. NF-kB inhibition, PepT1 uptake, IBD and colitis evidence, oral dosing, and clinical observations.

Selank vs Semax: Anxiolytic vs Nootropic Compared
Selank vs Semax comparison by Dr. Julian Douwes. GABAergic anxiolytic vs dopaminergic nootropic — mechanisms, evidence, dosing, and which to choose.

Probiotics vs. Prebiotics vs. Postbiotics: What the Difference Means for Your Gut
Physician guide to probiotics, prebiotics, postbiotics, and synbiotics. Definitions, mechanisms, when to use each, and how they work together for gut health.

Pentosan Polysulfate Eye Toxicity: Maculopathy Risk
Pentosan polysulfate maculopathy explained by Dr. Julian Douwes. Retinal toxicity risk, screening guidelines, reversibility questions, and what every PPS user must know.

Best Curcumin Supplements for Absorption: Meriva, BCM-95, Theracurmin, and Piperine Compared
Physician comparison of curcumin formulations for absorption. Meriva, BCM-95, Theracurmin, NovaSOL, and piperine ranked by bioavailability data, clinical evidence, and cost.

Metformin Side Effects for Anti-Aging Users: What to Watch For
Complete guide to metformin side effects in non-diabetics using it for longevity. B12 depletion, GI issues, exercise blunting, muscle loss risk, and mitigation strategies.

Brain Fog and Neuroinflammation: The PET Scan Evidence
What causes brain fog in Lyme disease — Johns Hopkins PET scan findings showing glial activation, neuroinflammation mechanisms, and treatment implications.

Berberine Dosage for Blood Sugar: Evidence-Based Protocol
Physician guide to berberine dosing for blood sugar, insulin sensitivity, and metabolic health. Optimal doses, timing, GI management, and comparison to metformin.

BPC-157 Side Effects: What the Evidence Actually Shows
Honest assessment of BPC-157 side effects, safety data, FDA warnings, and theoretical risks. What we know, what we don't, and what to watch for.

Omega-3 Dosage for Inflammation: EPA and DHA for Joints, Brain, and Heart
Evidence-based omega-3 dosing for inflammation. How much EPA and DHA for joint pain, cardiovascular inflammation, neuroinflammation, and autoimmune conditions. Physician protocols.

Functional vs Conventional Lab Ranges: Why Yours Differ
Why functional medicine blood test ranges differ from conventional lab ranges. TSH, vitamin D, ferritin, fasting glucose — what 'normal' really means and why it matters.

HHV-6 and Lyme Disease: The Co-Reactivation Problem
Why HHV-6 reactivates in virtually all chronic Lyme patients, its contribution to neurological symptoms, and testing and treatment approaches.

PEMF vs TENS vs Red Light: Comparing Energy Therapies
Head-to-head comparison of PEMF, TENS, and red light therapy. Mechanisms, evidence, best use cases, and how to choose the right energy therapy for your condition.

GI-MAP vs Standard Stool Culture: Which Test to Choose
Comparing GI-MAP qPCR stool testing with standard stool culture. Detection rates, pathogen coverage, clinical utility, and when each test is the right choice.

Hyperthermia for Cancer: Evidence, Protocols, and Clinical Experience
Hyperthermia cancer treatment evidence from RCTs and 35 years of clinical use. How moderate and extreme WBH synergize with chemo and radiation therapy.

Bartonella and Neuropsychiatric Symptoms
How Bartonella infection causes anxiety, rage, OCD, and psychiatric symptoms — the NC State research, diagnostic challenges, and treatment approaches.

EBV Reactivation: When Epstein-Barr Comes Back
Why Epstein-Barr virus reactivates in chronic illness, how it drives fatigue and immune dysfunction, and what treatment options exist for reactivated EBV.

Metformin vs. Berberine: AMPK Activators Compared
Head-to-head comparison of metformin and berberine for longevity, AMPK activation, blood sugar, and exercise compatibility. Evidence, dosing, and which to choose.

Clearing Brain Fog After Treatment: Recovery Timeline
What to expect during brain fog recovery after Lyme treatment — the multi-system recovery approach, realistic timelines, and evidence-based strategies.

Neuropsychological Testing for Brain Fog: When and Why
When to get neuropsychological testing for brain fog. What the evaluation measures, how it differs from standard neurology exams, and what the results mean for treatment.

Photobiomodulation for Brain Fog: Mitochondrial Rescue
How photobiomodulation targets mitochondrial dysfunction to clear brain fog. Mechanism, clinical evidence, and practical application for chronic illness patients.

PBM vs Red Light Therapy: What's the Difference?
Photobiomodulation vs red light therapy explained. Terminology, wavelengths, clinical vs consumer devices, and why the distinction matters for brain health.

Magnesium Deficiency Symptoms: The Warning Signs Most People Miss
Physician guide to magnesium deficiency symptoms including muscle cramps, insomnia, anxiety, heart palpitations, and fatigue. Testing, causes, and how to correct it.

NAC for Fertility: How N-Acetyl Cysteine Supports Reproductive Health
Evidence-based guide to NAC for fertility in men and women. PCOS, ovulation, sperm quality, oxidative stress, and dosing protocols from clinical trials.

Rapamycin vs Metformin for Longevity: A Head-to-Head Comparison
A physician's honest comparison of rapamycin and metformin for longevity. mTOR inhibition vs AMPK activation, evidence quality, dosing, and who should use which.

Heavy Metal Testing: Blood vs Urine vs Provoked
Comparing heavy metal testing methods. When blood testing, unprovoked urine, and provoked (post-chelation) urine are appropriate, and the controversy around each.

Anti-Inflammation Protocol
A physician's evidence-based protocol for reducing chronic inflammation through diet, lifestyle, and targeted supplementation.

CIRS vs MCAS: Overlapping Conditions Differentiated
How to distinguish CIRS from MCAS, why they frequently co-occur, and why treating only one often fails. HLA-DR genetics, mast cell activation, and the upstream driver.

Lyme Disease, Gut Dysbiosis, and Leaky Gut
How Lyme disease disrupts the gut microbiome. Antibiotic-driven dysbiosis, Borrelia's effect on intestinal permeability, the Hopkins microbiome findings, and recovery strategies.

Low NK Cell Function: What It Means and What to Do
Understanding low natural killer cell function in chronic illness. What NK cells do, why function drops, how to test, and evidence-based strategies to restore immune surveillance.

Hyperthermia Side Effects and What to Expect During Treatment
Honest guide to whole-body hyperthermia side effects. What happens during treatment, common reactions, Herxheimer responses, recovery timeline, and contraindications.

Babesia vs Malaria: Intraerythrocytic Parasites Compared
How Babesia and malaria parasites differ in transmission, symptoms, diagnostics, and treatment — and why Babesia is often called the malaria of the North.

Herxheimer Reaction vs Disease Flare: How to Tell the Difference
A clinical framework for distinguishing Jarisch-Herxheimer reactions from disease flares in Lyme treatment — timing, symptom patterns, and when to act.

GHK-Cu for Skin: Anti-Aging Evidence and Protocols
GHK-Cu copper peptide for skin anti-aging. Collagen synthesis, wrinkle reduction evidence, topical vs injectable protocols, and retinol comparison.

Magnesium Glycinate vs. L-Threonate: Which Form for Sleep, Anxiety, and Brain Health?
Physician comparison of magnesium glycinate vs magnesium L-threonate. Which form for sleep, which for cognition, absorption differences, dosing, and evidence quality.

Quercetin as a Senolytic: Protocol, Dosage, and What the Research Shows
Physician guide to quercetin senolytic protocols. Quercetin + dasatinib evidence, quercetin + fisetin alternatives, dosing schedules, and the science of clearing senescent cells.

Nattokinase and Serrapeptase for Biofilm Disruption
How proteolytic enzymes nattokinase and serrapeptase degrade biofilm matrix components — mechanism, dosing, evidence, and clinical considerations.

Senolytics: Clearing Senescent Cells
How senolytic therapies target zombie cells that drive aging. Dasatinib, quercetin, fisetin -- evidence, protocols, and honest limitations.

The Vagus Nerve and Inflammation: Cholinergic Anti-Inflammatory Pathway
How the vagus nerve controls inflammation through the cholinergic anti-inflammatory pathway. Mechanism, clinical significance, and implications for chronic illness.

GHK-Cu Dosage: Topical, Injection, and Combination Protocols
Complete GHK-Cu dosing guide. Topical concentrations, subcutaneous injection protocols, microneedling delivery, and combination strategies.

Thymosin Alpha-1 Dosage and Protocol
Evidence-based Thymosin Alpha-1 dosing. Subcutaneous protocols for immune support, cancer adjunct, infection, and chronic disease applications.

Epithalon Dosage: Telomere Protocol and Cycling
Evidence-based Epithalon dosing guide. Injection protocols, 10-20 day cycling, annual scheduling, and telomere monitoring from Dr. Julian Douwes.

Selank Dosage: Nasal Spray Protocol and Cycling
Evidence-based Selank dosing guide. Intranasal spray protocols, cycling schedules, stacking considerations, and what I observe in clinical practice.

NK Cells: Natural Killer Cells and CD57
What NK cells do, why CD57 matters in Lyme disease, and how to support natural killer cell function. By Dr. Julian Douwes.

Lymphocyte Subset Panel: Reading Your Immune Profile
How to read a lymphocyte subset panel. What CD4, CD8, CD19, and CD56 cells do, what abnormal ratios mean in chronic illness, and when this test changes your treatment.

Chronic Inflammation: The Root of Disease
How chronic low-grade inflammation drives disease, what causes it, and evidence-based strategies to address it. By Dr. Julian Douwes.

Cold Showers vs. Ice Baths: What Brown Fat Research Actually Shows
Physician analysis of cold showers versus ice baths for brown fat activation, fat loss, and metabolic health. Temperatures, durations, and what the thermogenesis data says.

Dihexa Dosage: Nootropic Protocol and Safety
Dihexa dosing guide by Dr. Julian Douwes. Oral and subcutaneous protocols, the c-Met safety question, and why caution is warranted with this potent nootropic peptide.

How to Read Your Microbiome Test Results
Practical guide to interpreting gut microbiome test results. Dysbiosis markers, keystone species, diversity metrics, and what your results actually mean for treatment.

Biofilm Disruption Protocols for Chronic Infections
A clinical overview of biofilm disruption strategies for persistent Lyme disease — the three-phase approach of disrupt, kill, and clear.

CIRS Symptom Checklist: HLA-DR Genetics and Biotoxin Illness
The 37 symptoms of CIRS across 13 clusters, HLA-DR genetic susceptibility, and why 25% of the population cannot clear biotoxins normally.

qEEG Brain Mapping: What It Shows and Who Needs It
Complete guide to quantitative EEG brain mapping. What the test measures, how it identifies brain dysregulation, and why it matters for neurofeedback and brain fog treatment.

BPC-157 Dosage Guide: Subcutaneous, Oral, and Injection Protocols
Evidence-based BPC-157 dosing protocols. Subcutaneous vs oral routes, loading vs maintenance, body weight calculations, and clinical observations.

CJC-1295/Ipamorelin for Weight Loss and Body Composition
CJC-1295/Ipamorelin for fat loss and body recomposition. Dr. Julian Douwes explains growth hormone mechanisms, realistic timelines, and what the evidence supports.

Fish Oil vs. Krill Oil vs. Algae Oil: Which Omega-3 Source Is Best?
Physician comparison of fish oil, krill oil, and algae oil for omega-3 supplementation. EPA and DHA content, absorption, sustainability, cost, and evidence-based recommendations.

LL-37 for Biofilm Disruption in Chronic Lyme
How LL-37 disrupts Borrelia biofilms in chronic Lyme disease. Mechanism, preclinical evidence, protocol context, and clinical observations.

Curcumin vs. Turmeric Supplements: Why the Spice Alone Is Not Enough
Physician guide to curcumin vs turmeric supplements. Why turmeric spice has poor bioavailability, how curcumin extracts differ, and what to look for in a supplement.

Heavy Metal Toxicity Symptoms by Metal Type
How mercury, lead, arsenic, cadmium, and aluminum affect the body differently. Symptom profiles by metal type, why they overlap with chronic illness, and when to test.

Biofilms: Why Infections Persist
How biofilms protect chronic infections from antibiotics and the immune system. Disruption strategies and clinical implications.

BPC-157 vs TB-500: Which Peptide for Tissue Repair?
A clinical comparison of BPC-157 and TB-500 for tissue repair. Mechanisms, evidence quality, best use cases, combination protocols, and what I observe in practice.

Thymosin Alpha-1 for Cancer: Immunotherapy Support
How Thymosin Alpha-1 supports cancer immunotherapy. T-cell activation, dendritic cell maturation, clinical trial data, and practical protocols.

Curcumin for Joint Pain and Arthritis: Dosage, Timeline, and What the Meta-Analyses Show
Evidence-based curcumin dosing for joint pain and arthritis. Meta-analysis results, comparison to NSAIDs, best formulations, timeline to improvement, and physician protocols.

Metformin Dosage for Longevity: What Non-Diabetics Need to Know
Evidence-based metformin dosing for anti-aging in non-diabetics. The TAME trial, MILES study dosages, titration protocols, and what physicians actually prescribe off-label.

Transcranial Photobiomodulation: Light Through the Skull
Evidence-based review of transcranial photobiomodulation for brain health. Wavelengths, mechanisms, clinical trial data, and what I see in practice.

Bartonella Stretch Marks (Striae): What They Mean
How to identify Bartonella-Associated Cutaneous Lesions (BACL) — the distinctive skin markings that mimic stretch marks and signal active Bartonella infection.

TB-500 Side Effects and Safety
Honest assessment of TB-500 side effects, WADA ban context, theoretical risks, and what clinical experience shows about Thymosin Beta-4 safety.

When to Take Magnesium: Morning vs. Night, With or Without Food
Physician guide to magnesium supplement timing. When to take glycinate, threonate, citrate, and other forms for maximum absorption and effect. Morning vs night, food interactions.

Lyme Disease False Negatives: Why Standard Tests Miss Chronic Lyme
Why Lyme disease tests come back negative in patients with active infection. ELISA sensitivity gaps, antibody window, seronegative Lyme, and what to do when tests miss.

Microbiome and Immunity: A Clinical Guide
How gut microbial diversity shapes immune function, and what testing and restoration strategies the evidence supports. By Dr. Julian Douwes.

Immune Support Protocol: Seasonal and Travel
A tiered protocol for immune support -- seasonal prevention, pre-travel preparation, and acute illness response. By Dr. Julian Douwes.

NAC Dosage Guide: How Much to Take for Liver, Lungs, and Immune Support
Evidence-based NAC dosing by condition. Liver support, respiratory health, immune function, mental health, and general antioxidant use. Physician-guided protocols.

Gentle Detoxification Protocol
A physician's approach to supporting liver, lymph, and toxin elimination through diet, supplements, and lifestyle. By Dr. Julian Douwes.

Intermittent Fasting for Longevity: What the Evidence Supports
Evidence-based review of intermittent fasting for longevity. Autophagy activation, metabolic health, biological age, and what I recommend in clinical practice.

The 12 Hallmarks of Aging: A Physician's Framework
All 12 hallmarks of aging from the 2023 Lopez-Otin update, explained through clinical practice. What each hallmark is, how to measure it, and what interventions target it.

Zone 2 Training: The Foundation of Cardiovascular Longevity
Why Zone 2 cardio is the single most important exercise modality for longevity. Mitochondrial biogenesis, fat oxidation, VO2 max, and practical programming.

Brain Fog Treatment: A Physician's Complete Guide
Brain fog treatment options from neuroinflammation workup to neuromodulation. Causes include post-COVID, Lyme, MCAS, and mold. TPS, NAD+, and hyperbaric oxygen covered.

How to Inject Peptides: A Step-by-Step Patient Guide
Step-by-step guide to subcutaneous peptide injection. Equipment, reconstitution, injection sites, rotation, storage, and sterility from a physician's perspective.

How Vaccines Interact with the Immune System
An evidence-based explanation of how vaccines work immunologically, including adjuvants, memory, and individual variation. By Dr. Julian Douwes.

Hormone Optimization for Women
Estrogen, progesterone, thyroid, and DHEA in aging women. Evidence-based approach to female hormonal health across perimenopause and beyond.

Telomere Health: Length, Telomerase, Epithalon
What telomere length means for aging, whether you can influence it, and the honest truth about telomerase activators and Epithalon.

Optimal vs Normal Lab Ranges: Why Your Doctor Says You're Fine
Why standard lab reference ranges miss early disease. Optimal ranges for TSH, ferritin, vitamin D, B12, fasting insulin, hsCRP, and why functional medicine testing matters.

Sleep Optimization Protocol
Evidence-based strategies for improving sleep quality -- environment, timing, supplements, and habits. By Dr. Julian Douwes.

H.E.L.P. Apheresis: How Blood Filtration Removes What Shouldn't Be There
How H.E.L.P. apheresis filters LDL, fibrinogen, CRP, and microclots from your blood. Mechanism, session details, evidence, and clinical experience at Klinik St. Georg.

Magnesium: 7 Forms Compared — Which One Do You Need?
Magnesium glycinate vs threonate vs taurate and 4 more forms compared. Dosing, deficiency signs, and why serum testing is unreliable. A physician's guide.

Histamine Intolerance: Beyond Allergies
Why histamine intolerance is a systemic condition, not just allergies. Mechanisms, diagnostic pitfalls, gut-immune connections, and treatment strategies from clinical experience.

Nattokinase: The Fibrinolytic Enzyme for Microclots
Evidence-based guide to nattokinase for fibrinolysis and microclots. Mechanism, dosing, post-COVID relevance, combination with serrapeptase, and safety with blood thinners.

Lyme Testing: Why Standard ELISA Fails
Why standard Lyme disease tests miss infections, and which advanced tests provide accurate results. ELISpot, CD57, and beyond.

Microbiome Testing: Stool Analysis Interpreted
What microbiome stool tests measure, how to interpret results, and which tests provide actionable clinical information. By Dr. Julian Douwes.

The Gut-Immune Axis: Where Immunity Begins
Why 70% of your immune tissue lives in the gut, and what this means for health, autoimmunity, and treatment. By Dr. Julian Douwes.

Thymus Function and T-Cell Health
How the thymus gland shapes immunity, why it declines with age, and what thymic peptide therapy can offer. By Dr. Julian Douwes.

Co-Infections: The Hidden Complexity
Overview of tick-borne co-infections -- Bartonella, Babesia, Ehrlichia, Mycoplasma -- and why treating Lyme alone is often insufficient.

Microclots and Endothelial Dysfunction
How microclots and damaged blood vessel linings drive post-COVID symptoms. Dr. Beate Jaeger's research and clinical implications.

The Longevity Blood Panel
What blood markers to test for longevity optimization, why standard panels are insufficient, and how to interpret results in context.

Stem Cell Therapy: What Works, What Doesn't
An honest assessment of stem cell therapy for longevity and regeneration. Separating science from marketing in the stem cell industry.

Metformin for Longevity
Can a diabetes drug slow aging? The TAME trial, mechanistic rationale, and honest assessment of metformin as a longevity intervention.

PEMF Therapy: Pulsed Electromagnetic Fields for Pain and Healing
Evidence-based review of PEMF therapy. Mechanisms, clinical evidence for pain, bone healing, inflammation, and tissue repair. What the research shows and what we observe in practice.

Whole-Body Hyperthermia for Lyme: Why 2 Sessions, Not 6
Why St. George Hospital uses 2 extreme hyperthermia sessions at 41.6-41.8°C for Lyme eradication, not 5-6 moderate sessions. The science behind the protocol.

Post-COVID Syndrome: Our Treatment Approach
How we treat Long COVID and post-COVID syndrome. Mechanisms, diagnostics, and a multimodal treatment program grounded in clinical experience.

EBV, CMV, and HHV-6 Reactivation
How Epstein-Barr virus, cytomegalovirus, and HHV-6 reactivate during immune compromise. Diagnosis, clinical significance, and treatment.

Chronic Fatigue Syndrome: A Physician's Complete Guide
A physician's complete guide to chronic fatigue syndrome. Mitochondrial dysfunction, immune dysregulation, diagnostic criteria, and the stepwise treatment approach we use at Klinik St. Georg.

Heavy Metal Testing and Toxicology Screening
How to test for heavy metals accurately, what the results mean, and when provocation testing is warranted. By Dr. Julian Douwes.

Immune Profiling: Lymphocyte Subsets and Cytokines
What immune profiling reveals about your health that standard blood work cannot. Lymphocyte subsets, NK cells, and cytokine panels explained.

Mast Cell Activation Syndrome (MCAS): A Clinical Guide
A physician's guide to MCAS — mechanism, symptoms, diagnostic criteria, treatment, and the connection to Lyme, mold, and EBV. Based on clinical experience treating patients with complex multi-system illness.

VO2 Max: The Strongest Predictor of How Long You Live
VO2 max predicts all-cause mortality more powerfully than smoking, diabetes, or hypertension. How to test it, what your number means, and how to improve it.

Photobiomodulation: Red and Near-Infrared Light for the Brain
Evidence-based review of transcranial photobiomodulation. How red and near-infrared light affects brain metabolism, the evidence for TBI, dementia, depression, and cognitive enhancement.

Are Peptides Legal? A 2026 Regulatory Guide
Comprehensive guide to peptide legality in 2026. FDA regulations, EU framework, Australia's scheduling, compounding pharmacy rules, and grey market risks explained by a physician.

Probiotics: Matching the Right Strain to the Right Condition
Evidence-based guide to probiotic strain selection. Which strains work for which conditions, when to avoid probiotics, CFU counts, spore-based vs traditional, and what I use in clinical practice.

Antibiotic Resistance and Alternatives
How antibiotic resistance affects chronic infection treatment and what alternatives exist. A physician's perspective on navigating a post-antibiotic landscape.

Chronic Lyme Disease: What Medicine Misses
What conventional medicine gets wrong about chronic Lyme disease, why standard treatment fails some patients, and our integrative approach.

Medical Treatment in Germany: A Complete Guide for International Patients
Everything international patients need to know about medical treatment in Germany. Visa, costs, insurance, travel logistics, and what to expect at Klinik St. Georg in Bad Aibling — based on treating patients from 90+ countries.

Autophagy: How Your Body Recycles Damaged Cells
How to activate autophagy through fasting, exercise, and targeted interventions. The science of cellular self-cleaning, its role in aging, and what actually works.

Sleep Architecture and Longevity
How sleep stages affect aging, recovery, and healthspan. Optimization strategies grounded in evidence and clinical experience.

Autoimmune Disease: Mechanisms and Treatment
Why the immune system attacks itself, what triggers autoimmunity, and how integrative medicine approaches treatment. By Dr. Julian Douwes.

How Often Should You Sauna? What the Longevity Evidence Shows
Physician analysis of sauna frequency for longevity based on the Finnish cohort studies. How often, how long, what temperature, and who should avoid it.

Hormone Optimization for Men
Testosterone, DHEA, thyroid, and growth hormone in aging men. Evidence-based approach to male hormonal health and longevity.

Blood Panels Decoded: Beyond the Standard CBC
What your standard blood work measures, what it misses, and which additional markers provide the most clinical value. By Dr. Julian Douwes.

Lion's Mane: Nerve Growth Factor and Cognitive Benefits
Evidence-based guide to lion's mane mushroom for brain health. NGF stimulation, cognitive benefits, dosing, extract types, and what the clinical data supports.

Mycoplasma and Chlamydia Pneumoniae
How Mycoplasma and Chlamydia pneumoniae establish chronic intracellular infection. Symptoms, diagnosis, and treatment approaches.

Post-COVID Brain Fog: Mechanisms and Treatment
Why COVID-19 causes persistent cognitive dysfunction and what can be done about it. Mechanisms, assessment, and treatment strategies.

Curcumin: Why Most Supplements Don't Work and Which Ones Do
The bioavailability problem with curcumin explained. Comparing Meriva, Longvida, BCM-95, Theracurmin, liposomal, and piperine forms. Dosing by condition.

How Much Deep Sleep and REM Do You Need? Sleep Architecture Explained
Physician guide to sleep stages, deep sleep and REM targets by age, and what your sleep tracker data actually means for longevity and cognitive health.

Apheresis for Long COVID: Removing Microclots and Restoring Circulation
How H.E.L.P. apheresis removes microclots and inflammatory mediators in Long COVID patients. Session protocols, evidence from Pretorius research, and clinical experience at Klinik St. Georg.

IV Laser Therapy and Immune Function
How intravenous laser therapy at different wavelengths affects immune cells. Evidence, mechanisms, and clinical applications by Dr. Julian Douwes.

Rapamycin and mTOR: Longevity's Most Debated Drug
How rapamycin inhibits mTOR to potentially slow aging. Evidence from animal studies, emerging human data, risks, and honest assessment.

Innate vs. Adaptive Immunity Explained
How your two immune systems work together to defend against infection and disease. A clear explanation from Dr. Julian Douwes.

Neuroborreliosis: When Lyme Crosses the Blood-Brain Barrier
How Borrelia invades the central nervous system, why neuroborreliosis is underdiagnosed, and how hyperthermia, TPS, and multimodal protocols treat what antibiotics alone cannot reach.

Contrast Therapy Protocol: Should You Sauna or Cold Plunge First?
Physician-guided contrast therapy protocol combining sauna and cold plunge. Optimal order, timing, temperatures, and what the cardiovascular evidence shows.

Methylene Blue: Mitochondrial and Antimicrobial
What methylene blue does at the mitochondrial level, its antimicrobial properties, and a conservative assessment of its longevity potential.

Vagus Nerve Stimulation: How to Activate Your Body's Calm System
Vagus nerve stimulation benefits explained by a physician. Invasive vs non-invasive VNS, cold exposure, HRV measurement, and clinical evidence for inflammation and depression.

Long COVID: Symptoms, Mechanisms, and What Actually Helps
A clinical guide to Long COVID symptoms and treatment based on 500+ patients. Microclots, spike protein persistence, endothelial dysfunction, and the therapies that produce measurable results.

Lyme Support Protocol: Between Treatments
A supplement and lifestyle protocol for Lyme disease patients between clinical treatments. Evidence levels included. By Dr. Julian Douwes.

Ashwagandha: Cortisol, Thyroid, and Evidence-Based Dosing
Evidence-based guide to ashwagandha. Cortisol reduction, thyroid effects, dosing, extract types, safety, and what the clinical data actually shows.

Research & Publications
Published research, conference presentations, and academic contributions from Dr. Julian Douwes and the St. George Hospital clinical team.

Why Patients Fly to Germany for Lyme Treatment
Why international patients seek Lyme disease treatment in Germany. Medical culture, treatment options, and what makes the German approach different.

Mitochondrial Medicine: The Energy Crisis
Why mitochondrial dysfunction underlies fatigue, cognitive decline, and aging. Testing, treatment, and what actually improves mitochondrial function.

What Is TMS? Transcranial Magnetic Stimulation Explained
Transcranial magnetic stimulation explained by a physician. TMS vs TPS, FDA clearance, session protocols, and why I rank TPS as the top neuromodulation tool in my practice.

Media & Speaking
Podcast appearances, conference talks, press mentions, and media inquiries for Dr. Julian Douwes.

Post-COVID Recovery Protocol
An evidence-based recovery protocol addressing inflammation, clotting, energy, and immune regulation after COVID-19. By Dr. Julian Douwes.

The Complete Thyroid Panel: What to Test and Why
TSH alone is not enough. A complete thyroid panel includes free T3, free T4, reverse T3, TPO and TG antibodies. How to interpret results and screen for Hashimoto's.
Ehrlichia and Anaplasma
Ehrlichiosis and anaplasmosis -- obligate intracellular co-infections that target white blood cells. Diagnosis, treatment, and clinical significance.

Lyme Disease Symptoms: The Complete Checklist Doctors Miss
Comprehensive Lyme disease symptom checklist covering neurological, musculoskeletal, cardiac, psychiatric, and GI manifestations. Based on treating 12,000+ Lyme patients at Klinik St. Georg.

Travel Health Protocol: Immune and Gut Support
A physician's travel protocol for immune support, jet lag management, and gut protection. Evidence-based recommendations by Dr. Julian Douwes.

Omega-3: EPA and DHA Dosing by Condition
Omega-3 EPA and DHA dosing guide by condition. Therapeutic vs maintenance doses, omega-3 index testing, fish oil vs algal, and quality markers. Evidence graded honestly.

Mistletoe Therapy (Iscador): Evidence in Integrative Oncology
Mistletoe extract (Iscador, Helixor) for cancer: mechanism, NK cell activation, quality of life evidence, injection protocols, and the German clinical tradition.

Cold and Heat Exposure for Longevity
Cold plunge and sauna protocols for healthspan. What the evidence shows about deliberate temperature stress and aging.

30-Day Gut Reset Protocol
A structured four-phase protocol for gut restoration -- remove, repair, reinoculate, maintain. Evidence-based by Dr. Julian Douwes.

NAC (N-Acetyl Cysteine): The Most Underrated Supplement in Medicine
NAC N-acetyl cysteine benefits reviewed by a physician. Glutathione precursor, psychiatric uses, liver protection, COVID research, and dosing from 600-1800mg.

Frequently Asked Questions
Answers to common questions about consultations, treatment at St. George Hospital, peptide therapy, costs, insurance, and how to work with Dr. Julian Douwes.

St. George Hospital: Where Theory Meets Practice
Klinik St. Georg in Bad Aibling, Germany -- one of Europe's leading integrative medicine hospitals with 35+ years of experience treating patients from 90+ countries.

Mold Illness and CIRS
Chronic Inflammatory Response Syndrome from mold exposure. How it overlaps with chronic infections, diagnosis, and treatment approaches.

IHHT: Intermittent Hypoxia-Hyperoxia Training
How IHHT simulates altitude training to improve mitochondrial function. Evidence, protocols, and clinical applications.

NAD+ IV Therapy: Cellular Energy and Aging
How NAD+ IV therapy supports mitochondrial function and cellular repair. Evidence, clinical experience, and what patients should know.

Neurofeedback for ADHD: Does It Work?
Neurofeedback for ADHD reviewed honestly. EEG mechanism, theta/beta ratio, clinical trial evidence, limitations, session requirements, and realistic expectations from a physician.

Cognitive Performance Protocol
Evidence-based protocol for mental clarity, focus, and memory from a physician who treats cognitive dysfunction daily.

CoQ10: Ubiquinol vs Ubiquinone — What Actually Matters
Evidence-based guide to CoQ10 supplementation. Ubiquinol vs ubiquinone, absorption differences, statin interactions, mitochondrial function, and what I recommend in clinical practice.

Cytokine Storms: When Immunity Goes Wrong
What causes a cytokine storm, how it damages the body, and what physicians can do about it. A clinical explanation by Dr. Julian Douwes.

Best Supplements for Deep Sleep: Evidence Ranked
Physician-ranked guide to sleep supplements. Magnesium glycinate, glycine, apigenin, L-theanine, and ashwagandha compared by evidence quality for deep sleep enhancement.

Apheresis for Chronic Infections
How therapeutic apheresis filters inflammatory mediators, autoantibodies, and microclots. Applications in post-COVID and chronic infection treatment.

Biological Age Testing
Epigenetic clocks, pace of aging, and how to measure how fast you are actually aging. What the tests mean and their limitations.

Semaglutide: Beyond Weight Loss — A Physician's Assessment
An evidence-based clinical assessment of semaglutide. GLP-1 mechanism, cardiovascular benefits, neuroprotective signals, muscle loss concerns, and who should and should not use it.
Babesia: The Parasitic Co-Infection
How Babesia differs from bacterial co-infections, why it requires antiparasitic treatment, and clinical signs that suggest Babesia involvement.

Immune Modulation: Enhancing or Calming Immunity
How physicians enhance weak immune responses and calm overactive ones. Evidence-based immune modulation explained by Dr. Julian Douwes.

Bartonella: The Stealth Pathogen
Bartonella infection -- symptoms, diagnostic challenges, treatment approaches, and why this co-infection is often the primary driver of illness.

Herxheimer Reactions: What They Are
Understanding Jarisch-Herxheimer reactions during infection treatment. Why symptoms worsen before improving and how to manage the process.

How to Increase Deep Sleep Naturally: A Physician's Protocol
Evidence-based protocol to increase deep sleep and slow-wave sleep. Temperature, light, exercise timing, supplements, and what actually works according to sleep research.

Building Your Longevity Stack
Evidence-tiered approach to longevity supplements. What works, what might work, and what to skip -- from a physician's perspective.

TMS for Depression: What 20 Years of Evidence Shows
TMS depression treatment reviewed by a physician. FDA clearance history, rTMS protocols, theta burst stimulation, response rates, and who responds best.

Integrative Oncology: What It Is and What It Is Not
A clinician's guide to integrative oncology. What complementary therapies have evidence, how they work alongside conventional treatment, and what 35 years of clinical experience at Klinik St. Georg have shown.

Morning Protocol: Cold, Light, and Supplements
Dr. Julian Douwes' personal morning protocol -- cold exposure, morning light, and foundational supplements with evidence levels.

What Is Whole-Body Hyperthermia? A Complete Guide
Whole body hyperthermia treatment explained by a physician. How controlled fever therapy works for Lyme, cancer, and post-COVID at St. George Hospital.

Fisetin: The Senolytic Flavonoid You Should Know About
Fisetin senolytic dosing, Mayo Clinic research, mechanism of action, combination with quercetin, and honest evidence grading from a physician who uses senolytics in clinical practice.

Pre-Treatment Preparation Protocol
How to prepare your body before traveling to St. George Hospital for Lyme, Post-COVID, or integrative cancer treatment.

Functional Medicine Labs: OAT, DUTCH, GI-MAP
A clinical guide to organic acids testing, DUTCH hormone testing, and GI-MAP stool analysis -- what they measure and when to use them.

Hormone Panels: What to Test and When
Which hormones to test, when to test them, and how to interpret results using optimal ranges rather than just reference ranges.

Testosterone After 40: What Every Man Should Know
Evidence-based guide to testosterone optimization after 40. Testing, natural decline, the optimization ladder from lifestyle to TRT, risks, benefits, and monitoring — from a physician who treats it daily.

Dihexa: The Cognitive Peptide with Limited Data
Dihexa peptide review by Dr. Julian Douwes. Potent cognitive peptide, HGF/c-Met mechanism, extremely limited human data, and why caution is warranted.

BPC-157: What the Research Actually Shows
Honest physician's assessment of BPC-157 peptide. Mechanisms, animal vs human evidence, dosing, safety, and clinical observations from Dr. Julian Douwes.

KPV: The Anti-Inflammatory Tripeptide for Gut Health
KPV peptide review by Dr. Julian Douwes. Anti-inflammatory tripeptide derived from alpha-MSH, researched for IBD and gut healing. Evidence and clinical use.

Thymosin Alpha-1: The Immune Modulator with Real Data
Thymosin Alpha-1 review by Dr. Julian Douwes. Approved in 35+ countries, backed by human clinical trials. Immune modulation for infections and cancer support.

Selank: The Anxiolytic Peptide from Russia
Selank peptide review by Dr. Julian Douwes. Russian-developed anxiolytic and nootropic peptide, nasal administration, BDNF modulation, and evidence assessment.

Dihexa Safety: The c-Met Cancer Risk Question
Dihexa safety analysis by Dr. Julian Douwes. The HGF/c-Met oncogenic pathway concern, retracted research, failed clinical trials, and what patients must understand.

Pentosan Polysulfate: Beyond Bladder Conditions
Pentosan polysulfate (PPS) review by Dr. Julian Douwes. FDA-approved for IC, emerging osteoarthritis evidence, unique mechanism, and clinical applications.

CJC-1295/Ipamorelin: Growth Hormone Secretagogues
CJC-1295 and Ipamorelin review by Dr. Julian Douwes. Growth hormone optimization, body composition, evidence for GH secretagogues, dosing and safety.

Peptide Sourcing: Hospital-Grade vs. Grey Market
Guide to peptide sourcing and quality. Compounding pharmacies vs research chemicals, testing standards, what to look for, and why source matters for safety.

Peptide Therapy for Lyme Disease
How Dr. Julian Douwes uses peptides in chronic Lyme disease treatment. Thymosin alpha-1, LL-37, BPC-157 protocols alongside standard Lyme therapy.

GHK-Cu: The Copper Peptide for Tissue Remodeling
GHK-Cu copper peptide review. Gene expression modulation, wound healing, skin rejuvenation, and anti-aging research assessed by Dr. Julian Douwes.

TB-500: Thymosin Beta-4 for Tissue Repair
Evidence-based review of TB-500 peptide for tissue repair and wound healing. Mechanisms, research status, dosing, and clinical perspective from Dr. Julian Douwe

Peptide Therapy for Gut Healing
How BPC-157, KPV, and LL-37 support gastrointestinal repair. Dr. Julian Douwes explains peptide protocols for IBD, leaky gut, and gut barrier dysfunction.

Epithalon: Telomerase Activation and Anti-Aging
Epithalon peptide review by Dr. Julian Douwes. Telomerase activation, longevity research, limited human data, and the telomere-cancer question examined honestly

LL-37: The Antimicrobial Peptide for Innate Immunity
LL-37 antimicrobial peptide review by Dr. Julian Douwes. Innate immunity, biofilm disruption, Lyme disease applications, and clinical perspective.

DSIP: Delta Sleep-Inducing Peptide for Sleep
DSIP peptide review by Dr. Julian Douwes. Delta sleep-inducing peptide for sleep regulation, stress resilience, and neuroendocrine balance. Evidence assessment.

Peptide Therapy for Recovery and Performance
BPC-157 and TB-500 for injury recovery, surgical healing, and athletic performance. Evidence-based protocol from Dr. Julian Douwes.

Peptide Safety: What You Need to Know
Comprehensive guide to peptide therapy safety. Regulatory status, quality concerns, side effects, contraindications, and why physician oversight matters.

Blog | Julian Douwes M.D.
Evidence-based articles on peptides, longevity, Lyme disease, immunology, and integrative medicine by Dr. Julian Douwes M.D. Clinical insights from Klinik St. Georg.

Gut-Brain Axis: How Healing Your Gut Can Transform Brain and Mood Health
The bidirectional gut-brain axis governs mood, cognition, and immune balance. Dr. Julian Douwes explains the science and integrative protocols for restoring this critical communication pathway.